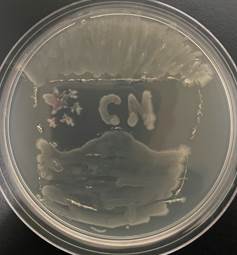
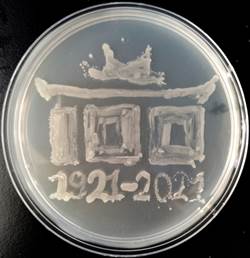

12月21日,学院在生物化工研究所举行第三届微生物培养皿艺术设计大赛。大赛由《微生物学实验》授课教师王远鹏、王海涛主持。2018级生物工程本科生参加赛事。
比赛设置“平板作画”和 “培养皿艺术创作”双赛道:“平板作画”赛道要求参赛选手以培养基为画板,以牙签、接种环做画笔,以菌液做颜料,借助微生物实验技术,用细菌在培养基平板上作画。“培养皿艺术创作”赛道要求参赛学生充分发挥想象力,利用各种绘图及设计软件对《微生物学实验》授课期间显微镜观察所拍摄的原图进行二次图像处理形成艺术作品。
比赛过程中,选手们认真投入,精心构思,仔细雕琢,一幅幅精美的培养皿艺术作品浮现在眼前。大赛共收到76幅作品,投稿数量远超往届,作品内容涵盖建筑、风景、人物、卡通形象等多个领域。经过评委公平公正的评审,“平板作画”赛道共评选出一等奖2名,二等奖4名,三等奖9名;“培养皿艺术创作”共评选出一等奖2名,二等奖4名,三等奖3名。
本次比赛是一场科学和艺术的“相逢”,也是一个“耐心铸造奇迹”的过程,充分展示了我校生物工程学生的科学素养,也生动展现出生物学科的独特魅力。未来,《微生物学实验》课程将继续秉承“育人为本、德育为先”教学理念,不断深化教学改革,提升育人工作成效,以优异的工作、显著的成绩献礼百年校庆。
附获奖名单:
一、“平板作画”赛道
一等奖:沈子涵 王子钺
二等奖:廖 亮 张佳臣 张姗姗 王晓涵
三等奖:邱煜哲 张文光 叶思雨 莫隽彬 赵誉泽 颜心怡
王安琪 许更新 李振俊
二、“培养皿艺术创作”赛道
一等奖:王琪琪 王宇杰
二等奖:邱静霞 刘宜昆 武顺妹 李汶阐
三等奖:雷航彬 侯逸雪 姜 旭
部分获奖作品展示:
(平板作画一等奖作品——抗疫医生:作者以大肠杆菌为画笔在牛肉膏蛋白胨培养基上勾勒出生动的抗疫医生形象,戴着防护帽和口罩,护目镜上清晰地映衬出五星红旗)

(平板作画一等奖作品——大肠杆菌书法家:作者以大肠杆菌为画笔,在牛肉膏蛋白胨培养基上用小篆书写了社会主义核心价值观“自由”“平等”“公正”“法治”)
(平板作画二等奖作品——献礼百年:作者以大肠杆菌为画笔,在牛肉膏蛋白胨培养基上勾勒以厦门大学群贤、建南楼群等嘉庚建筑风格标志,呈现出厦门大学百年办学历程)

(培养皿艺术创作一等奖作品——吴桂伐树:作者将之前显微镜拍摄的细菌染色图片视为吴桂伐树时树木震动落下的花瓣,添加了树木和人物后呈现出一幅完整的作品)

(培养皿艺术创作一等奖作品——千里之行始于足下:作者将显微镜观察拍摄到的霉菌装片上的菌丝视为行走路上的小草,与人物和背景一起构成一幅浑然天成的作品)